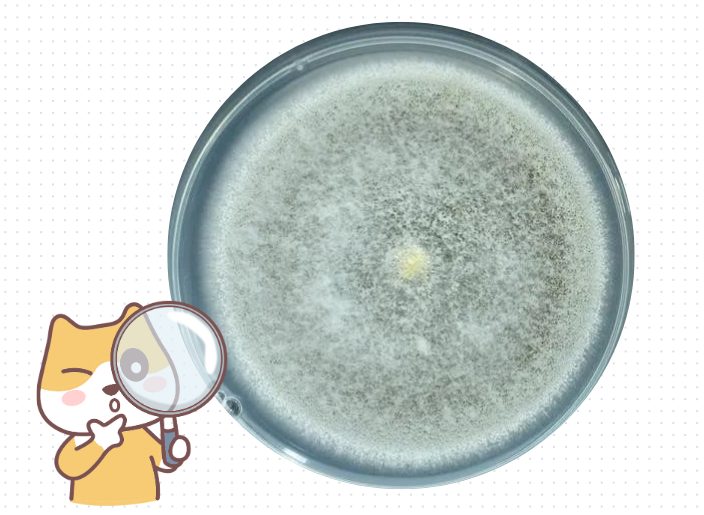
怎么确定猫咪是不是得了猫癣？

猫癣是猫咪最常见的皮肤病之一,尤其是在多猫家庭中,一旦有一只猫感染了猫癣,就很可能会迅速传播给其他猫咪,甚至会影响主人的健康。因此,早期发现并给予正确的处理十分重要。那么,怎么确定猫咪得了猫癣呢?今天就来给大家介绍一些简单的检查方法。

1.观察症状
大部分猫癣是由犬小孢子菌感染引起的,通常会引起以下症状表现:
●猫咪身上有一处或多处脱毛,形成圆形或椭圆形的脱毛斑块,与周围皮肤的边界十分明显。
●脱毛区域周围的毛发十分干枯脆弱,容易脱落或断裂。
●脱毛区域上面可能会有灰色或白色的鳞屑和红斑。
●病情严重时,癣斑上可能伴随瘙痒、结痂、溃疡等症状。

2..伍德式灯检查
伍德氏灯可以发出一种窄谱紫外线,可以用来快速诊断猫癣。在伍德氏灯下,犬小孢子菌的代谢产物通常会发出绿色荧光反应。检查的时候要确保猫咪的皮肤上没有涂抹任何药水,且检查环境光线较弱。

需要注意的是,并非所有真菌都会产生这种反应,所以即使没有反应也不能完全排除猫癣的可能性。
3.皮肤刮片检查
皮肤症状和伍德氏灯检查都只是猫癣的初步诊断方法,如果想要获得更准确的检查结果,建议前往宠物医院进行皮肤刮片检查。
兽医会采取受感染区域的皮肤刮片,然后在显微镜下检查刮片样本。如果发现真菌的菌丝体或孢子,就可以确诊为猫癣。

4.真菌培养
这是诊断真菌感染最准确的方法,兽医会采取病变处的皮肤组织、血液等,放入培养基后培育一段时间,最后在显微镜下观察真菌的形态和菌丝特征。
这种方法可以确定真菌的种类,可以帮助后续给猫咪选择合适的抗真菌药物治疗。
如果确诊为猫癣,建议及时使用抗真菌药物给猫咪治疗。
✔常用的外用药有达适宁(复方酮康唑软膏)、皮普特(盐酸特比萘芬喷剂)、克霉唑软膏等,可以用于感染范围较小的猫癣。
✔对于感染范围较广的猫癣,可以考虑配合药浴治疗,比如0.2%恩康唑溶液、2~4%石硫合剂等,每周1~2次。
✔如果是比较顽固或较为严重的猫癣,在使用外用药物治疗的基础上,还需要配合口服伊曲康唑,每日1次,每次5~10mg/kg。但这种药物容易对猫咪的肝功能造成损伤,所以3月龄以下的幼猫、孕猫及肝功能不好的猫咪不能使用。
在治疗过程中,注意定期对猫咪的生活环境消毒,保持环境干燥、卫生。另外,适当给猫咪补充维生素、蛋白质和不饱和脂肪酸,有助于皮肤修复。